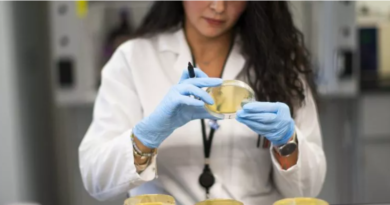

Hoy lunes protocoliza la renuncia del director de Migración Colombia, Christian Krüger.
Este lunes el director de Migración Colombia Christian Krüger Sarmiento le notificará a todos los funcionarios de Migración Colombia que decidió retirarse del Gobierno, tras 5 años de labores.
Se trata de uno de los pocos funcionarios que venían de la administración Santos a los que el presidente Iván Duque decidió retener.
Y se convirtió en pieza fundamental dentro de la política estatal de cara a la masiva migración de venezolanos que llegaron a nuestro país.
De hecho, fue el único director de entidad nacional que fue ratificado, decisión en la que influyó el respaldo que le dio el entonces canciller Carlos Holmes Trujillo, ahora Ministro de Defensa.
“Señor presidente, aun cuando hemos alcanzado importantes metas y logros, luego de 5 años al frente de Migración Colombia, y más de 10 años al servicio del Estado colombiano, he decidido que ha llegado la hora de dar un paso al costado, buscar nuevos rumbos y dedicar más tiempo a mi familia. Por consiguiente, de la manera más atenta y respetuosa, presento a usted y a la señora ministra de relaciones exteriores, mi renuncia irrevocable al cargo”, dice en su misiva.